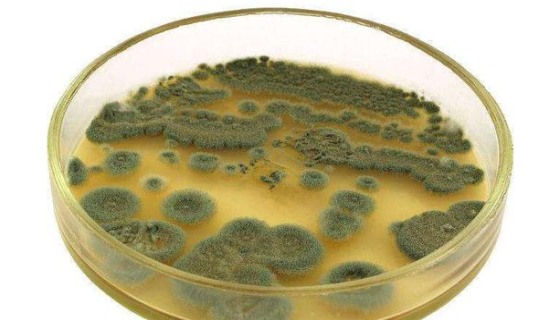
灰黄青霉的知识简介与代谢产物及培养方法！
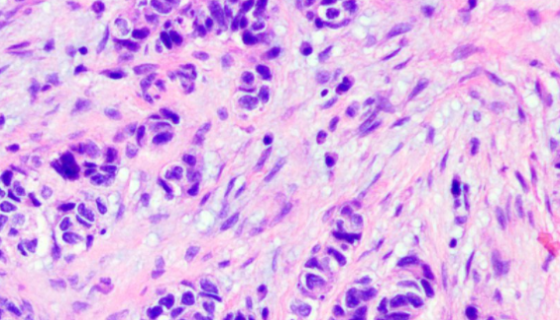
人髓母细胞瘤组织源细胞的分离方法与质量检测！
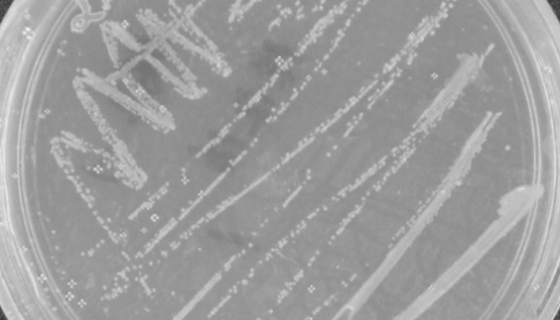
叶片微杆菌的培养方法与实验内容及使用范围！

大鼠胰岛素瘤细胞的复苏操作要点及应用!
大鼠胰岛素瘤细胞分离自大鼠胰岛素瘤组织是指从机体的组织或器官...
灰黄青霉的知识简介与代谢产物及培养方法!
灰黄青霉,菌落质地絮状厚密;菌落颜色浅绿色;菌落表面有放射状...

HBMEC人脑微血管内皮细胞的传代培养及应用!
HBMEC人脑微血管内皮细胞是血脑屏障的主要组成成分,能够限...
人髓母细胞瘤组织源细胞的分离方法与质量检测!
人髓母细胞瘤组织源细胞分离自癌组织;癌(cancer)是指起...

柴油食烷菌的形态特征与主要价值及打管说明!
柴油食烷菌是Alcanivorax属的微生物,原产地为中国。...

小鼠膀胱癌细胞接收后的操作流程与培养步骤!
小鼠膀胱癌细胞接收后的处理方法与培养步骤及注意事项有哪些?
叶片微杆菌的培养方法与实验内容及使用范围!
叶片微杆菌是Microbacterium属的微生物,原产地为...

小鼠乳腺上皮细胞的分离方法与质量检测!
小鼠乳腺上皮细胞分离自乳腺组织;乳腺是复管泡状皮肤腺,主要由...

MDCK犬肾细胞的培养操作步骤及应用!
MDCK犬肾细胞是由S·H·Madin和N·B·Darby在...